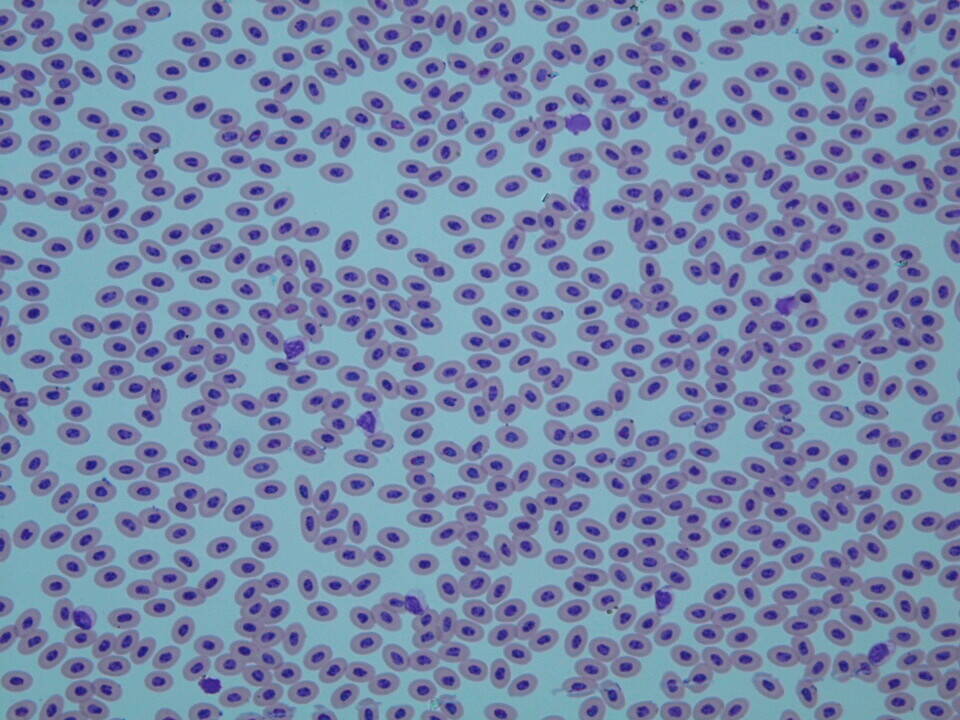
2019トピック0811_1_ヒナイドリ.jpg
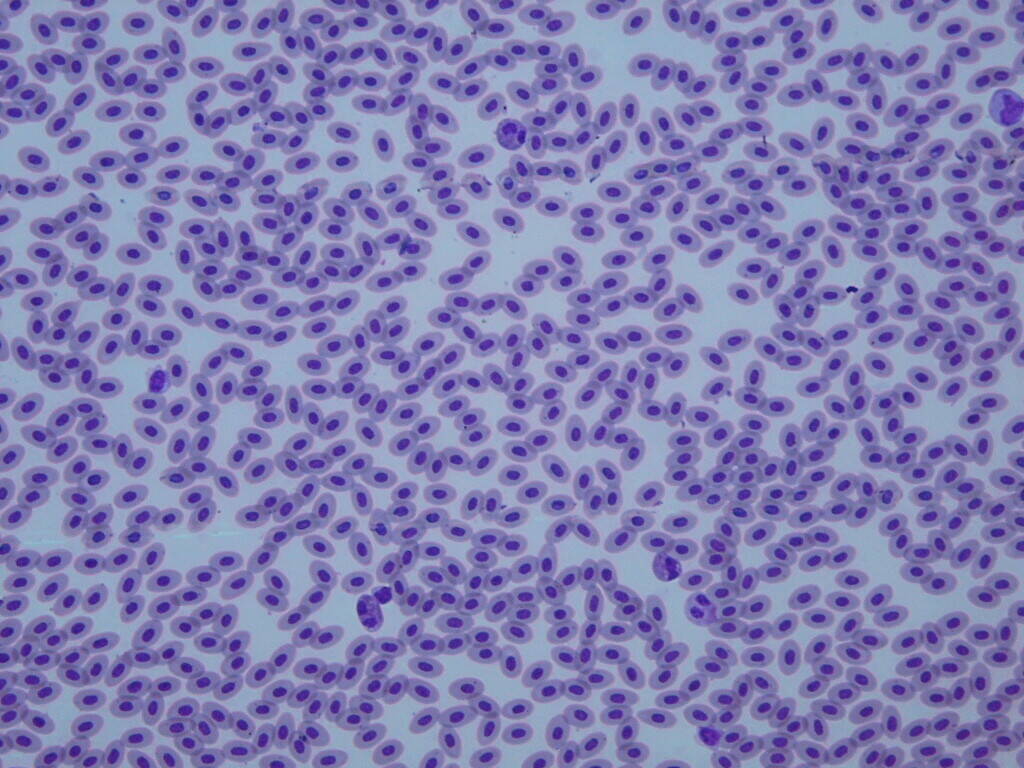
2019トピック0811_2_ゴイシチャボ.jpg
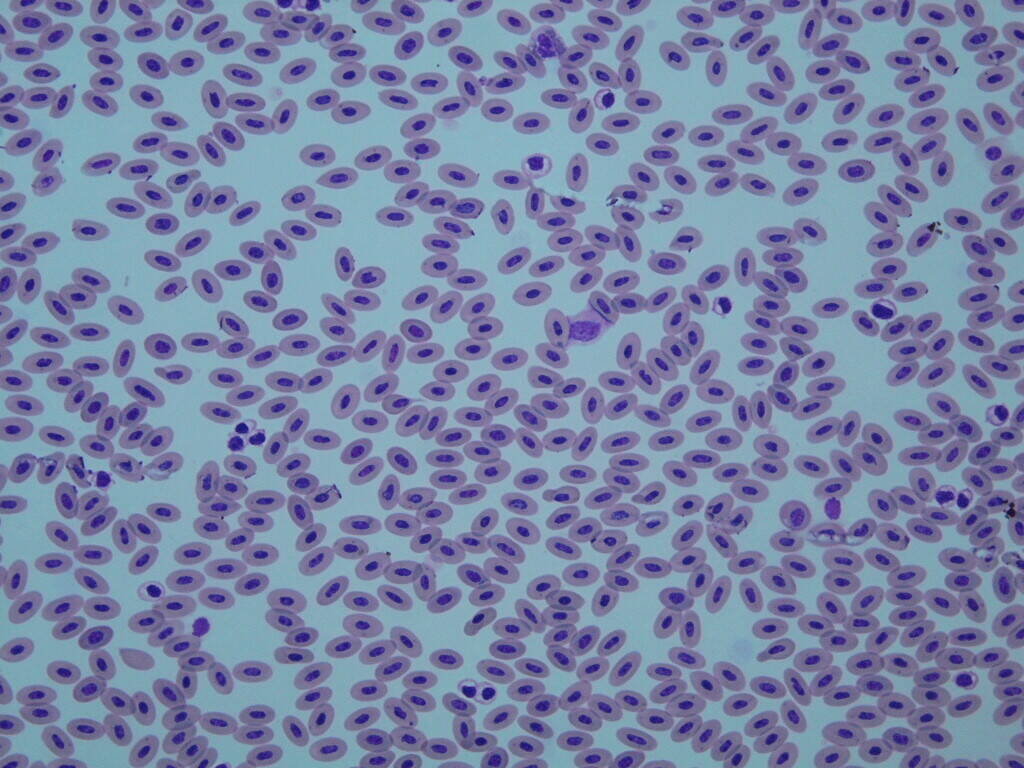
2019トピック0811_3_ニホンキジ.jpg

更新日:2019.08.11いろいろな動物の赤血球のお姿 2.鳥類編
更新日:2019.08.11
いろいろな動物の赤血球のお姿 2.鳥類編
赤血球ファンのみなさまこんにちは!以前ご紹介しました哺乳類の赤血球(こちら)はいかがでしたか?ずいぶん間が空いてしまいましたが、今日は鳥類の赤血球をご覧いただきます。鳥類の赤血球は楕円形で核があり、哺乳類とは異なるお姿です。写真は血液塗抹(とまつ)標本、全て同じ拡大倍率です。
まずは、身近なニワトリをご覧ください。
ヒナイドリ、「なかよし広場」ではいちばん大きな体格です。
次はゴイシチャボ、広場では小さい方です。
両者そっくりで見分けがつきません。体格は違いますが同じニワトリなので当然?
では同じキジ科のニホンキジはいかがでしょうか?
ん!?ニワトリよりも微妙に全体的に長くて核が細いものが多い印象を受けます。
この微妙な差が気になり他の個体の標本も見てみたところ、やはりこの形でした。
しかしサイズも形も、同じキジ科、良く似ていますね!
カモ科はどうでしょう。当園の大きいのと小さいのを並べてみましょう。
まずは大きな方の、オオハクチョウ(ハクチョウ属)。「大池」でご覧になれます。
次に小さな方でコガモ(マガモ属)。「バードケージ」でご覧になれます。
おお!!コガモの方が一目見て小さいですね。これは検査時には全く気付いておりませんでした。(コーフンしてしまいました。)
今回お示ししたキジ科のニワトリとニホンキジでは、赤血球のお姿はとても良く似ていました。カモ科のオオハクチョウとコガモでは、見て取れるほどの大きさの差がありました。
この差には、どんな意味が隠されているのでしょうか。
オチも動物の写真も無くて、筆者は皆さまに退屈させてはいないかと心配しております。
鳥たちの方は、是非ご来園になってご覧いただければと思います。(飼育展示係 宗正)